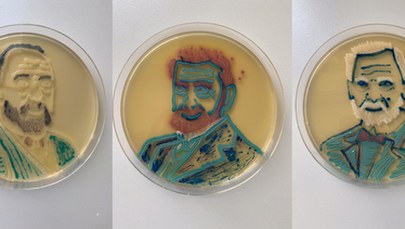
Tak wygląda sztuka mikrobiologii. Studentka z Poznania maluje bakteriami

Mamy złe informacje dla kierowców – w najbliższych dniach na drogach będzie ślisko. Wszystko za sprawą nadciągającego niżu Denise, który przyniesie nam z północy chłodne i wilgotne powietrze. "Pierwsze, intensywne opady śniegu już tej nocy" – ostrzega Grzegorz Walijewski z Instytutu Meteorologii i Gospodarki Wodnej.
Termometry pokażą dziś maksymalnie od -2 st. C. na północnym wschodzie kraju, ok. 2 st. C w centrum, do 4 st. C na zachodzie i nad morzem. Synoptycy zapowiadają opady deszczu ze śniegiem, deszczu i mżawki. Mogą one powodować gołoledź.
Grzegorz Walijewski z IMGW prognozuje, że w nocy z środy na czwartek nad Polskę nadejdzie układ niskiego ciśnienia Denise. Przyniesie on do naszego kraju wilgotne i chłodne powietrze. Oznacza to opady śniegu.
Szczególnie w południowych województwach tego śniegu może przybyć od 7 do nawet 15 cm. Wilgoć dotrze także do centralnej części kraju. Śnieg może pojawić się w województwie mazowieckim - mówi Walijewski.